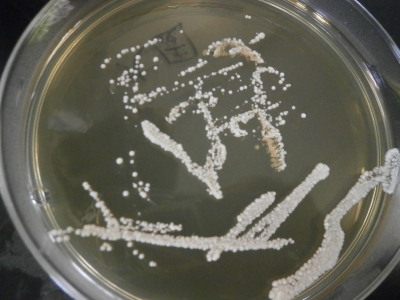

・食品科学科SPH COC+微生物実験技術研修Ⅳ(産学連携)
食品科学科2年生を対象として行っている微生物実験技術研修。今回で
4回目です。
前回と同様、講師は林田安生様(熊本大学くまもと地方産業
創生センターCOC+推進コーディネーター)です。また、鳥越商店の鳥越
秀夫様と堤酒造の堤有史様が聴講に来られました。
3日間培養し、培地に塗布した酵母がいい具合に増殖しています。今日
の研修では、まずこの酵母を観察します。

観察手順の説明の中では、「観察したい対象が見つからない!」という
トラブルを起こさないためのコツも教えていただきました。

培地から菌をとり、

スライドガラスにのせます。

カバーガラスをのせたら、

カバーガラスのすぐ横に水滴を落とします。これで準備完了!顕微鏡で
観察します。

大量の酵母がひしめき合う様子に驚く生徒も。時間はかかりましたが、
全生徒が増殖した酵母を確認することができました。

研修の後半では、酵母の育種や味噌醤油業界業界における技術開発等に
ついて学びました。
4月からは学校設定科目「醸造」が始まります。今回の研修で微生物へ
の関心が深まること、また学んだことを今後の学習に生かしてくれること
を期待します。